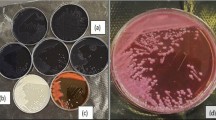

Abstract
A new strain isolated from activated sludge and identified as Burkholderia vietnamiensis C09V was used to biodegrade crystal violet (CV) from aqueous solution. To understand the degradation pathways of CV, batch experiments showed that the degradation using B. vietnamiensis C09V significantly depended on conditions such as pH, initial dye concentration and media components, carbon and nitrogen sources. Acceleration in the biodegradation of CV was observed in presence of metal ions such as Cd and Mn. More than 98.86C of CV (30 mg l−1) was degraded within 42 h at pH 5 and 30 °C. The biodegradation kinetics of CV corresponded to the pseudo first-order rate model with a rate constant of 0.046 h−1. UV–visible and Fourier transform infrared spectroscopy (FTIR) were used to identify degradation metabolites. Which further confirmed by LC-MS analysis, indicating that CV was biodegraded to N,N-dimethylaminophenol and Michler’s ketone prior to these intermediates being further degraded. Finally, the ability of B. vietnamiensis C09V to remove CV in wastewater was demonstrated.
Similar content being viewed by others
Explore related subjects
Discover the latest articles, news and stories from top researchers in related subjects.Avoid common mistakes on your manuscript.
Introduction
Wastewater from the textile industry has become a major environmental hazard in recent years and this effluent contains toxic dyes and heavy metals (Daneshvar et al. 2007). Many efforts have been made to develop strategies that treat dyes in wastewater, including physical, chemical and biological techniques. Physical and chemical methods are useful but their limitations include high cost, secondary pollutants and versatility (Forgacs et al. 2004). An alternative is biodegradation because it is cost-effective and environmentally friendly, and furthermore does not produce large quantities of sludge despite representing a slower rate of crystal violet (CV) biodegradation (Mohan et al. 2007).
A number of microorganisms has been reported to degrade crystal violet. The biodegradation of triphenylmethane dyes using white rot fungi has been reported, where biodegradation mechanisms of dyes depended mainly on the enzyme being secreted by white rot fungus (Cha et al. 2001). The degradation of CV using either Bacillus subtilis IFO 13719 or Nocardia corallina IAM 12121 has been documented (Yatome et al. 1993), where the CV at a low concentration was degraded, and it has been reported that bacterial process is much faster than fungal decolorisation/degradation of dyes (Garg et al. 2012). However, the growth of bacterial was completely inhibited at a higher concentration. More recently, the biodegradation of CV, malachite green and methyl violet B by Shewanella decolorationis NTOU1 suggested that biodegradation of these dyes involved a reduction to its leuco form (Chen et al. 2008). Staphylococcus epidermidis has been used to biodegrade CV, phenol red, malachite green, methyl green and Fuchsin with a high decolourisation capacity (Ayed et al. 2010). These bacteria are useful in the biodegradation of CV, but the majority of these dyes are chemically stable and resistant to its decomposition by microbial organisms. Therefore, isolating new strains is one option that may increase the capacity of biodegradation of dyes and help us to understand its mechanism.
In this study, a new bacterium—Burkholderia vietnamiensis C09V (B. vietnamiensis C09V)—was isolated from activated sludge at the Textile Printing & Dyeing Mill (Fuan, Fujian, China). B. vietnamiensis has been reported in the biodegradation of toluene (Kumar et al. 2008) and documented as: firstly, reducing the toxicity of nickel and uranium; and secondly, playing a role in the degradation of trichloroethylene (Nostrand et al. 2007). It has not, however, been reported as being used to biodegrade CV. Hence, this study aimed to: (1) biodegrade CV using B. vietnamiensis C09V under various conditions and examine the conditions affecting the biodegrading efficiency; (2) study the kinetics of biodegradation and the metabolites as confirmed by ultraviolet (UV), Fourier transform infrared spectroscopy (FTIR) and high-performance liquid chromatography-mass spectrometry (HPLC-MS), and propose the degradation of CV; and (3) degrade the CV in wastewater to determine whether or not B. vietnamiensis C09V has the potential to biodegrade CV.
Materials and methods
Cultivation medium and cultivation
All the chemicals used in the experiment were analytical reagent grade. CV (purity ≥ 96 %) was purchased from Sigma-Aldrich and used without further purification.
The phosphate-buffered basal medium (BM) was composed of (gram per liter of distilled water unless otherwise indicated): K2HPO4 1.8, NaH2PO4 · 12H2O 3.0, MgCl 0.1, KNO3 1.0 and glucose 3.0. Solid BM plate contains (in grams per liter of BM): agar 20. Luria–Bertani medium (LB medium) was composed of (in grams per liter): NaCl 10, peptone 10 and yeast extract 5. Flasks containing the medium were sterilised by autoclaving at 121 °C for 20 min.
Microorganism and sequence analysis of the16S rRNA gene
B. vietnamiensis C09V, a facultative anaerobic bacterium, was originally isolated from wastewater sludge collecting from the Textile Printing & Dyeing Mill based at Fuan, Fujian in China. The isolated strain was identified using Gram staining and morphology characteristics. The strain is Gram-negative stained, short rod-shaped and pink- to orange-pigmented as well as motile without flagellum. The colonies on the BM agar plate were round, smooth and translucent with entire margins. Further identification was done by employing 16S ribosomal RNA (rRNA) gene sequencing. A fragment of 16S rRNA was amplified using a Gene Amp PCR system (PE, USA). Sequencing on both strands of polymerase chain reaction (PCR)-amplified fragments was carried out using the dideoxy chain termination method in an ABI 3730 automated sequencer (Invitrogen, Shanghai, China). Using the basic local alignment search tool (BLAST) program (Nievas et al. 2006), 16S rRNA homology searches of the NCBI database were carried out, the aim being to find similar sequences in the 16S rRNA database. The phylogenetic tree was drawn using the bootstrap program MEGA (ver. 4.0).
Biodegradation experiments
Since the growth of this strain was much faster in LB medium (data not shown), strain C09V was first cultivated at 30 °C overnight in LB medium and then harvested by centrifugation (7,000 rpm, 10 min). The pellet was washed twice in 15 ml BM and then re-suspended in 10 ml BM. Cell suspension was transferred to a series of 50 ml culture bottles containing fresh BM (30 ml) using a gyratory shaker (SKY-2102, Shanghai, China) operated at 150 rpm in the dark. Sterile controls were prepared using autoclaved culture before the introduction of CV. The CV concentration following degradation in various samples was determined using UV–visible spectrophotometry. The biomass produced was determined following the methodology described (Silveira et al. 2009).
The wastewater containing crystal violet was collected from an industrial sewage treatment plant at Fuzhou, where the crystal violet concentration was 40.37 mg l−1 and pH was 8.59. The samples were stored at 4 °C before being used. Inoculum was added to wastewater (30 ml) in a 50 ml culture bottle at pH 5 and 30 °C in the dark for 72 h. Sterile control was used to compare this process to that of biodegradation. During the culture period, bacterial growth was monitored by spectrophotometry at 600 nm (Chen et al. 2009). Chemical oxygen demand (CODcr) was measured by a closed reflux titration method (Clesceri et al. 1999). The average values of the parallel measurements were used in all analyses and the standard deviations of these means.
Characterisations and measurements
Fourier transform infrared spectra (FTIR) concerning the ‘initial’ and ‘final’ sample of biodegradation of crystal violet were obtained with a Fourier transform infrared spectroscope (FTIR Nicolet 5700, Thermo, USA). Samples for FTIR measurement were prepared by mixing extracted metabolites with spectroscopically pure KBr in the ratio 1:100 and pressed into a sheer slice. An average of 16 scans was collected for each measurement with a resolution of 2 cm−1.
Aliquots of cell cultures (50 ml) collected after decolourisation of CV (100 mg l−1) were centrifuged at 10,000 × g for 10 min, and the collected supernatant collected was extracted with 100 ml of ethylacetate. The extracts were dried and evaporated with nitrogen gas; acetonitrile was added prior to LC/MS analyses. Metabolites were identified using liquid chromatography-mass spectrometry (HPLC/Q-TOF-MS, Bruker, Germany). A C18 analytical column (3.0 × 50 mm, 2.2 μm particle size) was used for the separation at 30 °C with an injection volume of 10.0 μl. The mobile phase consisted of a mixture of (A) methanol and (B) 5 mmol l−1 ammonium acetate in MilliQ water with a flow rate was 0.3 ml min−1. A linear gradient was applied starting at 35 % of (A), to 45 % of (A) in 2 min, up to 90 % in the next 7 min and at 90 % for 2 min, then to 35 % in 0.1 min and stay at 35 % for 2 min. The mass spectrometer was operated in positive ESI mode. The source conditions were as follows: end plate offset: −500 V, 91 nA; capillary: 4,500 V, nebuliser: 0.6 Bar; dry gas: 6.0 l min−1 and dry temperature: 180 °C.
CV concentration was measured using a UV–visible spectrophotometer (722 N, Shanghai, China) at 588 nm. The removal efficiency of crystal violet was calculated using the following equation (Parshetti et al. 2006):
where A 0 = the initial absorbance of the medium; and A e = the absorbance of decolourised medium.
Results and discussion
Phylogenetic analysis of B. vietnamiensis C09V
The 16S rRNA gene sequence of B. vietnamiensis C09V was deposited at GenBank under Accession No. JF922108. The sequences of the 16S rRNA gene of the strain were determined and compared to NCBI to match the closest by BLAST. The result indicated that the 16S rDNA sequences of the strain had up to 100 % similarity with a culture of B. vietnamiensis. Fig. 1 illustrates a phylogenetic tree construction based on 16S rRNA. It highlights the phylogenetic position of the B. vietnamiensis C09V strain and other related microorganisms, which were found in the NCBI GenBank database. Sequence comparison indicated that the B. vietnamiensis C09V strain was in the phylogenetic branch of B. vietnamiensis.
Phylogenetic tree of Burkholderia vietnamiensis C09V based on 16S rRNA gene sequence. (GenBank sequence accession numbers are given in parentheses. Bootstrap values > 50 % are indicated in the main nodes in a bootstrap analysis of 1,000 replicates; the scale bar represents the expected number of substitutions averaged over all sites analysed. Numbers at the nodes show the percent bootstrap value. Besides, the length of the nucleotide sequence considered is 1,422 bp, and Oxalicibacterium flavum strain TA17 was used as a bacterial outgroup.)
Effect of operational conditions
Effect of pH
Since culture medium pH can have an impact on enzyme activity, transport process and nutrient solubility (Kulkarni and Chaudhari 2007; Margesin and Schinner 2001), the effect of solution pH on the biodegradation of crystal violet was investigated, where initial culture medium pH values ranged from 4.0 to 8.0 after 42-h incubation. As shown in Fig. 2a, the degradation of crystal violet increased when pH rose from 4.0 to 5.0, and a further increase in pH from 5.0 to 8.0 caused a decline in the degradation of crystal violet. The highest level of removal of crystal violet occurred at pH 5.0. More than 96.4 % of crystal violet was degraded. Degradation, however, declined from 96.4 to 75.2 % when the pH ranged from 5.0 to 8.0. These results are consistent with the study that examined solubilising insoluble P using B. vietnamiensis, where the optimal pH ranged from 5.0 to 7.0 (Park et al. 2010). The increase in biodegradation as pH rose from 4.0 to 5.0 can be attributed to cells growing in size and hence increasing the enzyme concentration. However, the fall in degradation as pH increased can be explained by the cell growth becoming inhibited under alkaline conditions and hence reducing crystal violet degradation. In addition, the pH of the cultivation medium is likely to affect the CV due to its positive charge under alkaline conditions. This results in biodegradation by accepting electrons based on its pathway, where CV was first biotransformed into Michler’s ketone and N,N-dimethylaminophenol (Chen et al. 2008).
Factors affecting the biodegradation of CV. a Initial pH (initial concentration of crystal violet: 30 mg l−1; incubation time: 42 h; inoculum concentration: 0.4 % (v/v); temperature: 30 °C). b Temperature (pH 5.0). c Inoculum concentration (temperature: 30 °C; pH 5.0). d Initial dye concentration [inoculum concentration: 0.5 % (v/v)]
Effect of temperature
The effect of temperature ranging from 20 to 40 °C on the biodegradation of crystal violet was investigated (Fig. 2b), where biodegradation increased from 68.77 to 97.94 % when the temperature rose from 20 to 35 °C. When the temperature was increased further the degradation of crystal violet significantly decreased to 62.68 % at 40 °C. This is because the bacteria grew quickly within a relatively narrow temperature range and a higher temperature has a more adverse effect due to oxygen solubility falling when temperature increases; this triggers a reduction in the metabolic activity of aerobic bacteria (Bamforth and Singleton 2005). Generally, the biodegradation rate increases as temperatures also increase because this scenario favours bacterial growth, while harsh temperatures prohibit cellular enzymes, leading to a decrease in the degradation rate (Zavala et al. 2004). Nevertheless, the relatively higher degradation rates at temperatures ranging from 20 to 40, indicating that B. vietnamiensis C09V can be used to treat dye wastewater.
Effect of inoculum concentration
To estimate the optimum biomass of B. vietnamiensis C09V, the biodegradation of 30 mg l−1 crystal violet was monitored with inoculum concentrations from 2 to 7 %, which presented the inoculum concentrations of 6.26, 9.39, 12.52, 15.65, 18.78, and 21.91 mg l−1, respectively, as shown in Fig. 2c. It can be seen that dye removal significantly increased as the amount of biomass increased until it reached the value of 97.24 % at an inoculum concentration of 5 %. A similar observation was reported in the decolourisation of malachite green by Sphingomonas paucimobilis (Zavala et al. 2004). Further increase in the inoculum concentration did not accelerate the biodegradation since the existence of more bacteria populations resulted in increased competition for resources (e.g., nutrients and oxygen). This resulted in prohibited bacterial growth when limited nutrient resources were depleted (Mellefont et al. 2008), and OD600 increased from 0.037 to 1.5 when the value of dissolved oxygen decreased from 6.7 to 1.4 at an inoculum concentration of 5 %. It further indicated that the inoculum concentration of 5 % was suitable for degrading 30 mg l−1 crystal violet.
Effect of initial dye concentration
The effect of initial crystal violet concentration on biodegradation was examined to assess the strain’s tolerance of different concentrations of crystal violet (see Fig. 2d). This figure shows that B. vietnamiensis C09V could degrade crystal violet with a short lag time upon inoculation, and the adaptation period increased with higher crystal violet concentration. The degradation of 98.74 and 98.70 % was obtained after 36 h when initial concentration of crystal violet was 20 and 40 mg l−1, respectively, in the culture medium. As the initial concentration of crystal violet increased from 80 to 150 mg l−1, the degradation efficiency decreased from 92.88 to 46.91 % after 60 h.
It is suggested that the decrease in degradation efficiency might be due to the toxic effect of dyes on the growth of bacteria in the presence of dyes at toxic concentrations (Khehra et al. 2006). However, the amount of crystal violet removed increased when the initial concentration of crystal violet also rose, because a higher initial dye concentration provided a driving force that overcame all mass transfer resistances of the dye between the aqueous and solid phases (Parshetti et al. 2006). The tolerated high concentration (150 mg l−1) of crystal violet in the culture medium confirms that the B. vietnamiensis C09V strain has the potential to degrade crystal violet.
Effect of media composition
Effect of carbon source
Fig. 3a shows the effect of different carbon sources on the degradation of crystal violet over time through the addition of glucose, sucrose, starch and granulated sugar (3.0 g l−1) into the media containing the inoculated bacteria, and the control which did not have carbon sources. After 42-h incubation, the degradation efficiency of crystal violet was highest in the presence of glucose (98.8 %), followed by sucrose (86.7 %), granulated sugar food-sugar (78.9 %) and starch (78.9 %), while it was only 25.9 % when carbon sources were not added (control). This indicates that degradation activity of bacteria was linked to the carbon sources. However, the crystal violet in solution could also be used as a carbon source since 25.9 % crystal violet was removed in the control solution. These results correlate with the observation of the degradation of Blue G by C. versicolour using starch, molasses and fructose (Kapdan et al. 2000). Here, 100 % removal was achieved by glucose after 5-day incubation, followed by fructose (92 % in 9 days), starch and molasses (65 % in 9 days and 14 % in 6 days). This is probably due to the glucose being oxidised directly as an electron donor and being used by bacteria as energy material (Guo et al. 2010). However, sucrose and food-sugar were hydrolysed into either glucose or fructose, which can then be used by the B. vietnamiensis C09V strain. Soluble starch was hydrolysed into dextrin, then into maltose and finally into glucose, which can then be used by microorganisms (Guo et al. 2010). Hence, glucose as a carbon source was employed in this study since it is one of the co-substrates functioning as the electron donor in the biodegradation process (Telke et al. 2008).
Effect of nitrogen source
Fig. 3b shows the effect of different nitrogen sources on the degradation of crystal violet when peptone, beef extract, KNO3, NH4Cl and (NH4)2SO4 (1.0 g l−1) were added to the media inoculated with B. vietnamiensis C09V bacteria, while the control did not have nitrogen sources added to it. After 42-h incubation, the degradation of crystal violet was increased in the medium containing all tested nitrogen sources compared to the control. The degradation efficiency of crystal violet using different nitrogen sources occurred in the following order: KNO3 (96.1 %) > beef extract (63.8 %) > (NH4)2SO4 (61.1 %) > NH4Cl (51.6 %) > peptone (46.4 %) > control (42.2 %). This suggests that nitrogen sources present in the media affected dye decolourisation by altering bacteria’s production of enzymes (Kaushik and Malik 2009). In addition, the B. vietnamiensis C09V bacteria utilised either NO3 − or NH4 + which was formed by hydrolysis as N-source for the growth of microorganisms (Guo et al. 2010). It was reported that the complete decolourisation occurred: poly R-478 by Lentinus edodes at 1 mM NH4Cl nitrogen (in 18 days); 1 mM peptone nitrogen (in 21 days); and 2 mM malt extract nitrogen (in 17 days) (Hatvani and Mecs 2002). Therefore, KNO3 emerged as the most suitable nitrogen source in further experiments.
In summary, the best conditions for degrading 30 mg l−1 crystal violet by B. vietnamiensis C09V include 3 g l−1 glucose, 1 g l−1 KNO3, 5 % inoculum concentration, pH of 5 and a temperature of 35 °C. The results showed that 93.1 % crystal violet was removed within the first 30 h, and then 98.8 % crystal violet was degraded after 42-h incubation.
Effect of heavy metals
In addition to dyes, heavy metals are constantly present in textile effluent and they often inhibit or cease microbial growth (Sani et al. 2001). Hence, the influence of heavy metal ions on the degradation of CV by B. vietnamiensis C09V was examined by adding a number of heavy metals [Zn(II), Cu(II), Ni(II), Cd(II), Mn(II), Co(II)] to the solution. As shown in Fig. 3c, degradation of CV was enhanced only when 5 mM Cd(II) (98.3 %) was present and Mn(II) (93.6 %), compared to that in the control (92.7 %). Adding Mn(II) to the solution to enhance the degradation of CV was probably because Cd(II) and Mn(II) not only act as trace elements to promote the growth of the bacteria in media. They also play an essential role in the composition of enzymes and enzyme activation (Murugesan et al. 2009). This was observed by the presence of Mn(II) which enhanced the decolourisation of dyes using fungal strains since Mn(II) in solution promoted the production of enzymes.
However, the degradation of CV in the presence of Zn(II) (88.8 %) and Co(II) (91.8 %) was slightly lower than that of the control (92.7 %). This may be explained by the minor inhibitory effects of Zn(II) and Co(II) on the growth of bacteria and consequently reduced the degradation rate (Murugesan et al. 2009). In contrast to Cd(II) and Mn(II), the degradation of crystal violet was significantly reduced in the presence of Cu(II) (20.0 %) and Ni(II) (29.5 %) compared to the control (92.7 %), indicating that microbial growth was inhibited in the presence of Cu(II) and Ni(II) in the solution. This scenario was observed in the inhibitory effect of heavy metals on the growth of bacteria and hence inhibited dye decolourisation (Hatvani and Mecs 2002).
Kinetics of the biodegradation of CV by B. vietnamiensis C09V
Biodegradation kinetics was examined in order to understand the mechanism of microbial degradation and the prospect of application. In order to analyse the biodegradation kinetics of CV by B. vietnamiensis C09V, a number of kinetic models have been used to fit to the data. Of these, the pseudo first-order equation is well fitted to the experimental data. The pseudo first-order kinetic equation may be represented as follows (Lin et al. 2010):
where c is the concentration of CV (milligram per liter) at time t (hour), k is the first-order rate constant, and A is a constant.
It follows that the half-life of the CV biodegradation by B. vietnamiensis C09V can be expressed as:
Pseudo first-order parameters for the biodegradation of CV are listed in Table 1. The biodegradation rate constant increased from 0.019 to 0.046 with R 2 being more than 0.99 when the temperature increased from 20 to 35 °C, whereas it decreased to 0.017 as the temperature reached 40 °C, suggesting that high temperatures prohibited enzyme activity and enzymes become denatured when submitted to high temperatures. This results in a decrease in degradation rate, which was confirmed in the previous section. A similar trend for half-life was obtained and is listed in Table 1, where the half-life for CV biodegradation increased as initial temperature rose. This indicates that: firstly, the first-order rate model fitted well to the biodegradation of CV (30 mg l−1); and secondly, the specific biodegradation rate increases with a corresponding increase in initial temperature and then it slowed down (Zavala et al. 2004).
Characterisation of the biodegradation of CV by B. vietnamiensis C09V
UV–visible analysis
Fig. 4 illustrates the UV–vis spectra of crystal violet degraded by B. vietnamiensis C09V at 0, 24, 30 and 36 h, where UV–visible wavelength scanned from 200 to 800 nm and the initial concentration of CV was 30 mg l−1. It is evident that the spectra of crystal violet exhibit large peaks with a maximum at 588 and 300 nm, corresponding to the -C = C- bond and aromatic rings (Noubactep 2009). The peaks at 588 and 300 nm significantly declined after 24-h biodegradation. However, a new peak at 360 nm was observed after 30-h biodegradation, resulting from the formation of the metabolites by the degradation of CV (Asad et al. 2007). This suggests that the removal of CV by B. vietnamiensis C09V includes both bioadsorption and biodegradation, where peaks at 588 and 300 nm decrease approximately in proportion to each other in the adsorption of CV onto the biomass. In contrast the major peaks disappeared completely and a new peak appeared which resulted from the biodegradation of CV.
FTIR analysis
Initial and final biodegradation of the CV by B. vietnamiensis C09V scans were done in the range of 4,000–400 cm−1 wave numbers using an FTIR as shown in Fig. 5, where they show the differences in changes in bands before and after the biodegradation process. Before biodegradation (Fig. 5a), the bands at 3,440 and 2,918 cm−1 corresponded to N-H stretching vibration, the band at 1,590 cm−1 corresponded to C=C stretching vibrations, the band at 1,375 cm−1 corresponded to CH3 asymmetric bend, and the band at 802 cm−1 corresponded to benzene ring vibrations. However, a change in bands was observed following biodegradation due to the formation of metabolites as shown in Fig. 5b. Here, strong bands appeared at 1,460, 1,625, 1,242 and 884 cm−1 for C-H, C = O and C-O stretch vibrations and = C-H out of plane deformation vibration. In addition, two new bands at 1,737 and 3,220 cm−1 were also observed, corresponding to for = C–H, C = O, and C–O stretch vibrations. The change in bands clearly indicates that the formation of metabolites differs from the original substrate (Ayed et al. 2010).
FTIR analysis of the biodegraded products of CV by Burkholderia vietnamiensis C09V. a FTIR analysis of CV before biodegradation; b FTIR analysis the biodegraded products of CV after 36-h biodegradation. Numbers in the figure are absorption wave numbers for the stretching vibration of different functional groups
LC-MS analysis
Liquid chromatography-mass spectrometry was used for the analysis of degradation products formed during the biodegradation of CV by B. vietnamiensis C09V. The chromatograms from LC-MS obtained from samples before and after biodegradation are presented in Fig. 6a and Fig. 6b, respectively. The peak of CV was observed at a retention time of 9.0 min before biodegradation as shown in Fig. 6a. However, four new peaks (their retention time at 8.9, 6.7, 6.1 and 5.2 min) were observed in Fig. 6b after degradation, indicating the formation of four biodegradation products. Based on fragmentation pattern and m/z values, metabolites were identified as of leuco crystal violet, Michler’s ketone, [N,N-dimethylaminophenyl] [N-methylaminopheny]benzophenone and N,N-dimethylaminobenzaldehyde. As shown in Fig. 7, crystal violet was first bio-transformed into leuco crystal violet, followed by the asymmetric cleavage by dioxygenase action between carbon of aromatic ring and alkyl carbon resulted in N,N-dimethylaminophenol and Michler’s ketone. Then Michler’s ketone was demethylated to [N,N-dimethylaminophenyl] [N-methylaminophenyl] benzophenone or reductively split into N,N-dimethylaminobenzaldehyde and N,N-dimethylaminophenol. The results were observed by UV–vis and FTIR spectra as previously mentioned. It is reported that the filamentous fungus Cunning hamella elegans ATCC 36112 could degradate triphenylmethane dyes through sequential N-demethylation to N,N′,N′-trimethylpararosaniline (Cha et al. 2001). Similar reports indicate that the intermediates in the biodegradation of triphenylmethane dyes by Micrococcus sp. include 4-(dimethylamino)benzophenone, Michler’s ketone and 4-(methylamino)benzophenone (Du et al. 2013). Besides, the mechanism of crystal violet biodegradation was the reduction reaction, reductive splitting reaction and demethylation reaction (Chen et al. 2009).
Biodegradation of crystal violet in wastewater
To demonstrate whether B. vietnamiensis C09V can biodegrade crystal violet in wastewater, the crystal violet (40.37 mg l−1) in wastewater was removed gradually with the value of OD600nm increase from 0.038 to 0.793. In this scenario, 91.1 % crystal violet was degraded, accompanied by a large CODCr decrease from 1,094.1 to 72.9 mg l−1 after 72 h of incubation. Sterile controls indicated that there was no efficiency in the degradation process. The results further suggest that B. vietnamiensis C09V has the potential to effectively degrade crystal violet in wastewaters.
Conclusions
The results show that a new strain called B. vietnamiensis C09V can be used for the effective biodegradation of crystal violet. More than 98.86 % was degraded within 42 h at pH 5 and 30 °C, and the strain could degrade CV with high concentration (150 mg l−1) in the culture medium. The efficiency of CV biodegradation was increased with the presence of metal ions such as Cd and Mn, while other metal ions in the solution, such as Cu, could delay the process of CV degradation. The biodegradation kinetics of crystal violet corresponded to the pseudo first-order rate, with a rate constant of 0.046 h−1. UV–vis and FTIR reveal that crystal violet was adsorbed onto the B. vietnamiensis C09V biomass, and then it was biodegraded. The LC-MS analysis shows that crystal violet was biodegraded to N,N-dimethylaminophenol and Michler’s ketone prior to these intermediates being further degraded, and a possible biodegradation pathway of CV by B. vietnamiensis C09V was proposed. Finally, B. vietnamiensis C09V used to remove crystal violet from wastewater demonstrates this new strain has the potential to treat wastewater.
References
Asad S, Amoozegar M, Pourbabaee A, Sarbolouki M, Dastgheib S (2007) Decolorization of textile azo dyes by newly isolated halophilic and halotolerant bacteria. Bioresour Technol 98:2082–2088
Ayed L, Chaieb K, Cheref A, Bakhrouf A (2010) Biodegradation and decolorization of triphenylmethane dyes by Staphylococcus epidermidis. Desalination 260:137–146
Bamforth S, Singleton I (2005) Bioremediation of polycyclic aromatic hydrocarbons: current knowledge and future directions. J Chem Technol Biotechnol 80:723–736
Cha C, Doerge D, Cerniglia C (2001) Biotransformation of malachite green by the fungus Cunninghamella elegans. Appl Environ Microbiol 67:4358–4365
Chen C, Kuo J, Cheng C, Huang Y, Ho I, Chung Y (2009) Biological decolorization of dye solution containing malachite green by Pandoraea pulmonicola YC32 using a batch and continuous system. J Hazard Mater 172:1439–1445
Chen CH, Chang CF, Ho CH, Tsai TL, Liu SM (2008) Biodegradation of crystalviolet by a Shewanella sp. NTOU1. Chemosphere 72:1712–1720
Clesceri LS., Greenberg AE, Eaton AD (eds.) (1999) Standard methods for the examination of water and wastewater, 20th edn. American Public Health Association, American Water Work Association, Water Environment Federation, Washington, DC. APHA-AWWA-WEF
Daneshvar N, Ayazloo M, Khataee A, Pourhassan M (2007) Biological decolorization of dye solution containing Malachite Green by microalgae Cosmarium sp. Bioresour Technol 98:1176–1182
Du LN, Zhao M, Li G, Xu FC, Chen WH, Zhao YH (2013) Biodegradation of malachite green by Micrococcus sp. strain BD15: biodegradation pathway and enzyme analysis. Int Biodeterior Biodegrad 78:108–116
Forgacs E, Cserha’ti T, Oros G (2004) Removal of synthetic dyes from wastewaters: a review. Environ Internl 30:953–971
Garg SK, Tripathi M, Singh SK, Tiwari JK (2012) Biodecolorization of textile dye effluent by Pseudomonas putida SKG-1 (MTCC 10510) under the conditions optimized for monoazo dye orange II color removal in simulated minimal salt medium Int. Biodet Biodegrad 74:24–35
Guo MR, Lin YM, Xu XP, Chen ZL (2010) Bioleaching of iron from kaolin using Fe(III)-reducing bacteria with various carbon nitrogen sources. Appl Clay Sci 48:379–383
Hatvani N, Mecs I (2002) Effect of the nutrient composition on dye decolorisation and extracellular enzyme production by Lentinus edodes on solid medium. Enzyme Microb Technol 30:381–386
Kapdan IK, Kargia F, McMullanb G, Marchant R (2000) Effect of environmental conditions on biological decolourization of textile dyestuff by C. versicolor. Enzyme Microb Technol 26:381–387
Kaushik P, Malik A (2009) Fungal dye decolourization: recent advances and future potential. Environ Int 35:127–141
Khehra MS, Saini HS, Sharma DK, Chadha BS, Chimni SS (2006) Biodegradation of azo dye CI acid red 88 by an anoxic–aerobic sequential bioreactor. Dyes Pigments 70:1–7
Kulkarni M, Chaudhari A (2007) Microbial remediation of nitro-aromatic compounds: an overview. J Environ Manage 85:496–512
Kumar A, Dewulf J, Luvsanjamba M, Langenhove HV (2008) Continuous operation of membrane bioreactor treating toluene vapors by Burkholderia vietnamiensis G4. Chem Eng J 140:193–200
Lin C, Gan L, Chen ZL (2010) Biodegradation of naphthalene by strain Bacillus fusiformis (BFN). J Hazard Mater 182:771–777
Margesin R, Schinner F (2001) Biodegradation and bioremediation of hydrocarbons in extreme environments. Appl Microbiol Biotechnol 56:650–663
Mellefont L, McMeekin T, Ross T (2008) Effect of relative inoculum concentration on Listeria monocytogenes growth in co-culture. Int J Food Microbiol 121:157–168
Mohan SV, Rao N, Sarma P (2007) Simulated acid azo dye (acid black 210) wastewater treatment by periodic discontinuous batch mode operation under anoxic–aerobic–anoxic microenvironment conditions. Ecol Eng 31:242–250
Murugesan K, Kim YM, Jeon JR, Chang YS (2009) Effect of metal ions on reactive dye decolorization by laccase from Ganoderma lucidum. J Hazard Mater 168:523–529
Nievas ML, Commendatore MG, Olivera NL, Esteves JL, Bucalá V (2006) Biodegradation of bilge waste from Patagonia with an indigenous microbial community. Bioresour Technol 97:2280–2290
Nostrand JV, Khijniak T, Neely B, Sattar M, Sowder A, Mills G, Bertsch P, Morris P (2007) Reduction of nickel and uranium toxicity and enhanced trichloroethylenedegradation to Burkholderia vietnamiensis PR1301 wit hydroxyapatite amendment. Environ Sci Technol 41:1877–1882
Noubactep C (2009) Characterizing the discoloration of methylene blue in Fe0/H2O systems. J Hazard Mater 166:79–87
Park K, Lee O, Jung H, Jeong J, Jeon Y, Hwang D, Lee C, Son H (2010) Rapid solubilization of insoluble phosphate by a novel environmental stress-tolerant Burkholderia vietnamiensis M6 isolated from ginseng rhizospheric soil. Appl Microbiol Biotechnol 86:947–955
Parshetti G, Kalme S, Saratale G, Govindwar S (2006) Biodegradation of malachite green by Kocuria rosea MTCC 1532. Acta Chim Slov 53:492–498
Sani RK, Peyton BM, Brown LT (2001) Copper induced inhibition of growth of Desulfovibrio desulfuricans G20: assessment of its toxicity and correlation with those of zinc and lead. Appl Environ Microbiol 67:4765–4772
Silveira E, Marques PP, Silva SS, Lima-Filho JL, Porto ALF, Tambourgi EB (2009) Selection of Pseudomonas for industrial textile dyes decolourization. Int Biodeterior Biodegrad 63:230–235
Telke A, Kalyani D, Jadhav J, Govindwar S (2008) Kinetics and mechanism of reactive red 141 degradation by a bacterial isolate Rhizobium radiobacter MTCC 8161. Acta Chim Slov 55:320–329
Yatome C, Yamada S, Ogawa T, Matsui M (1993) Degradation of crystal violet by Nocardia corallina. Appl Microbiol Biotechnol 38:565–569
Zavala ML, Funamizu N, Takakuwa T (2004) Temperature effect on aerobicbiodegradation of feces using sawdust as a matrix. Water Res 38:2406–2416
Acknowledgements
This research was supported by Fujian Provincial Development and Reform Commission.
Author information
Authors and Affiliations
Corresponding author
Additional information
Responsible editor: Robert Duran
Rights and permissions
About this article
Cite this article
Gan, L., Cheng, Y., Palanisami, T. et al. Pathways of reductive degradation of crystal violet in wastewater using free-strain Burkholderia vietnamiensis C09V. Environ Sci Pollut Res 21, 10339–10348 (2014). https://doi.org/10.1007/s11356-014-3037-y
Received:
Accepted:
Published:
Issue Date:
DOI: https://doi.org/10.1007/s11356-014-3037-y